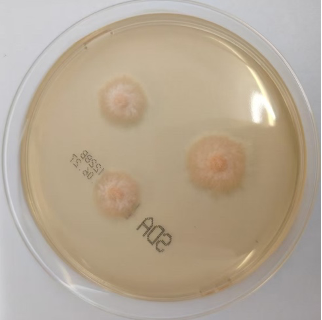
图片

院内新闻
【技术领航】精准检验锁定致盲元凶!市二院多学科联合攻克罕见混合病原体角膜溃疡!
内容提要
近日,葫芦岛市第二人民医院眼科与检验科紧密协作,依托微生物精准鉴定技术,成功诊治一例由金黄色葡萄球菌合并轮枝镰刀菌引起的复杂性角膜溃疡。该病例因病原体组合罕见、诊断明确、疗效显著,入选全国性高水平学术平台“京港感染论坛”,标志着我院在感染病学领域的技术能力已达国内先进水平。
71岁的李奶奶因右眼突发红痛、畏光、流泪并伴异物感,自行使用滴眼液一周未见好转,到葫芦岛市第二人民医院眼科就诊,诊断为“右眼角膜溃疡”并收治入院。看似普通的眼部症状背后,实为两种罕见病原体共同作用的严重感染。
“患者若再延误治疗,溃疡可能迅速进展至角膜穿孔,导致永久性失明。”眼科骨干医师张雪松在表面麻醉下为患者施行右眼角膜溃疡清创术,并采集病灶标本送检。术中发现溃疡已侵犯至角膜基质深层,根据临床经验,初步判断为真菌性角膜炎。在等待检验结果期间,团队果断开展针对性抗真菌治疗,使病情得到初步控制——角膜浸润静止,上皮逐步修复,眼内炎症减轻。
六天后,检验科微生物组组长王连飞带来关键报告:一般细菌培养显示为金黄色葡萄球菌(MSSA),真菌培养结果则为镰刀菌。至此,真相大白——患者为金黄色葡萄球菌合并轮枝镰刀菌引起的混合感染。
△梅里埃VITEK2 GP鉴定卡:金黄色葡萄球菌(鉴定率99%)
△金黄色葡萄球菌药敏实验VITEK2 GP63
△葡萄球菌青霉素抑菌圈边缘试验(抑菌圈边缘模糊提示不产β-内酰胺酶)
△沙保罗琼脂培养基(含氯霉素)培养四天
△35℃培养四天纯菌落乳酸酚棉蓝染色镜下形态
△中原质谱鉴定:轮枝镰刀菌
明确病原后,治疗团队迅速调整方案,以抗真菌为核心,联合抗细菌、促进角膜修复及控制眼内炎症等综合治疗。由于诊断精准、用药到位,患者病情迅速好转。半月后视力提升至0.7,角膜溃疡愈合,上皮完整,病灶范围明显缩小。随访显示,溃疡区仅残留小片云翳,对视功能影响已降至最低。
值得一提的是,轮枝镰刀菌的培养与鉴定技术难度极高,在全国范围内能成功分离并确诊该菌的案例极为少见。本例角膜溃疡分泌物中培养出轮枝镰刀菌的病例,也因此被国内感染病学领域极具影响力的“京港感染论坛”收录发表,充分彰显我院在病原体检测与复杂感染诊疗方面的技术实力。
本例罕见混合感染角膜溃疡的成功诊治,得益于葫芦岛市第二人民医院眼科精准临床判断与检验科强大技术支持。在多学科紧密协作下,即使面对复杂罕见的病原体感染,也能通过快速的病原鉴定和精准的个体化治疗,为患者守住光明,缔造生命的奇迹。
王连飞
副主任技师
·葫芦岛市第二人民医院检验科微生物组组长
专业特色:从事临床检验工作二十余年,擅长细菌、病毒、真菌等病原微生物的分离鉴定与分子诊断,尤其擅长疑难罕见病菌的培养、鉴定及多种耐药菌联合药敏检测。曾成功培养出轮枝镰刀菌、产气荚膜梭菌等罕见细菌,并协助临床制定治疗方案,帮助患者康复。在参加卫生部临床检验中心和辽宁省临床检验中心组织的细菌室间质量评价中均取得优异的成绩,多次参加全国细菌耐药监测网提高班培训,曾荣获“优秀员工”“先进防疫个人”等荣誉称号。
张雪松
副主任医师
·葫芦岛市第二人民医院眼科核心骨干
·国际AO-CMF眼眶修复高级研究会会员
·辽宁省养生康复学会眼底病慢病管理专委会第一届委员
专业特色:从事眼科临床工作十余年,多次前往上海复旦大学附属九院、中国医科大学附属第一医院进修深造,并先后在沈阳、大连、抚顺等三甲医院担任眼科骨干医师。完成各类眼科手术累计近万例,擅长眼底病、眼眶病、眼表疾病的诊断和手术治疗。对于眼底病、青光眼、白内障等疾病的激光治疗经验丰富。多次获得“优秀医生”、“最美医生”等称号,在各类医学论坛发表多篇文章。

上一篇:【技术领航】36分钟极速救援!葫芦岛市二院胸痛中心实现“城乡秒通”,高效响应跑赢“救心”黄金时间! 下一篇:【技术领航】放疗不只抗癌,治疗这些良性疾病也有奇效!










 统一呼叫平台
统一呼叫平台